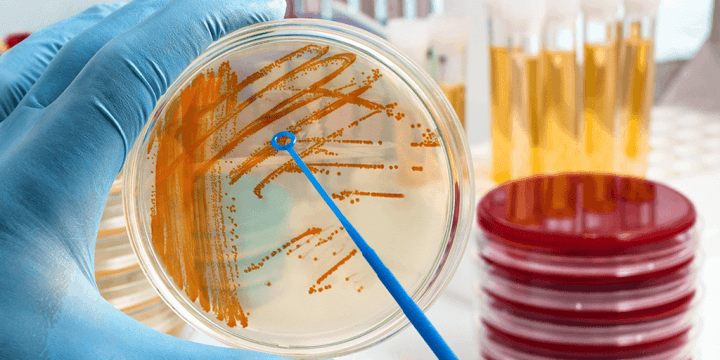

115 月 2018 by superlab.tw
2812 月 2017 by superlab.tw
199 月 2017 by superlab.tw
環保署草案人用防蚊液需毒理檢測才能上架販售
環保署規劃 人用防蚊液需毒理檢測才能上架販售 環保署今天發出新聞稿表示,將修正「環境用藥許可證申請規定」,把人用防蚊液主管機關從衛福部改為環保署外,也規定防蚊液成品也需做毒理檢測後才能上架販售,最快年底上路。 行政院環境保護署毒物及化學物質局今天發出新聞稿預告...